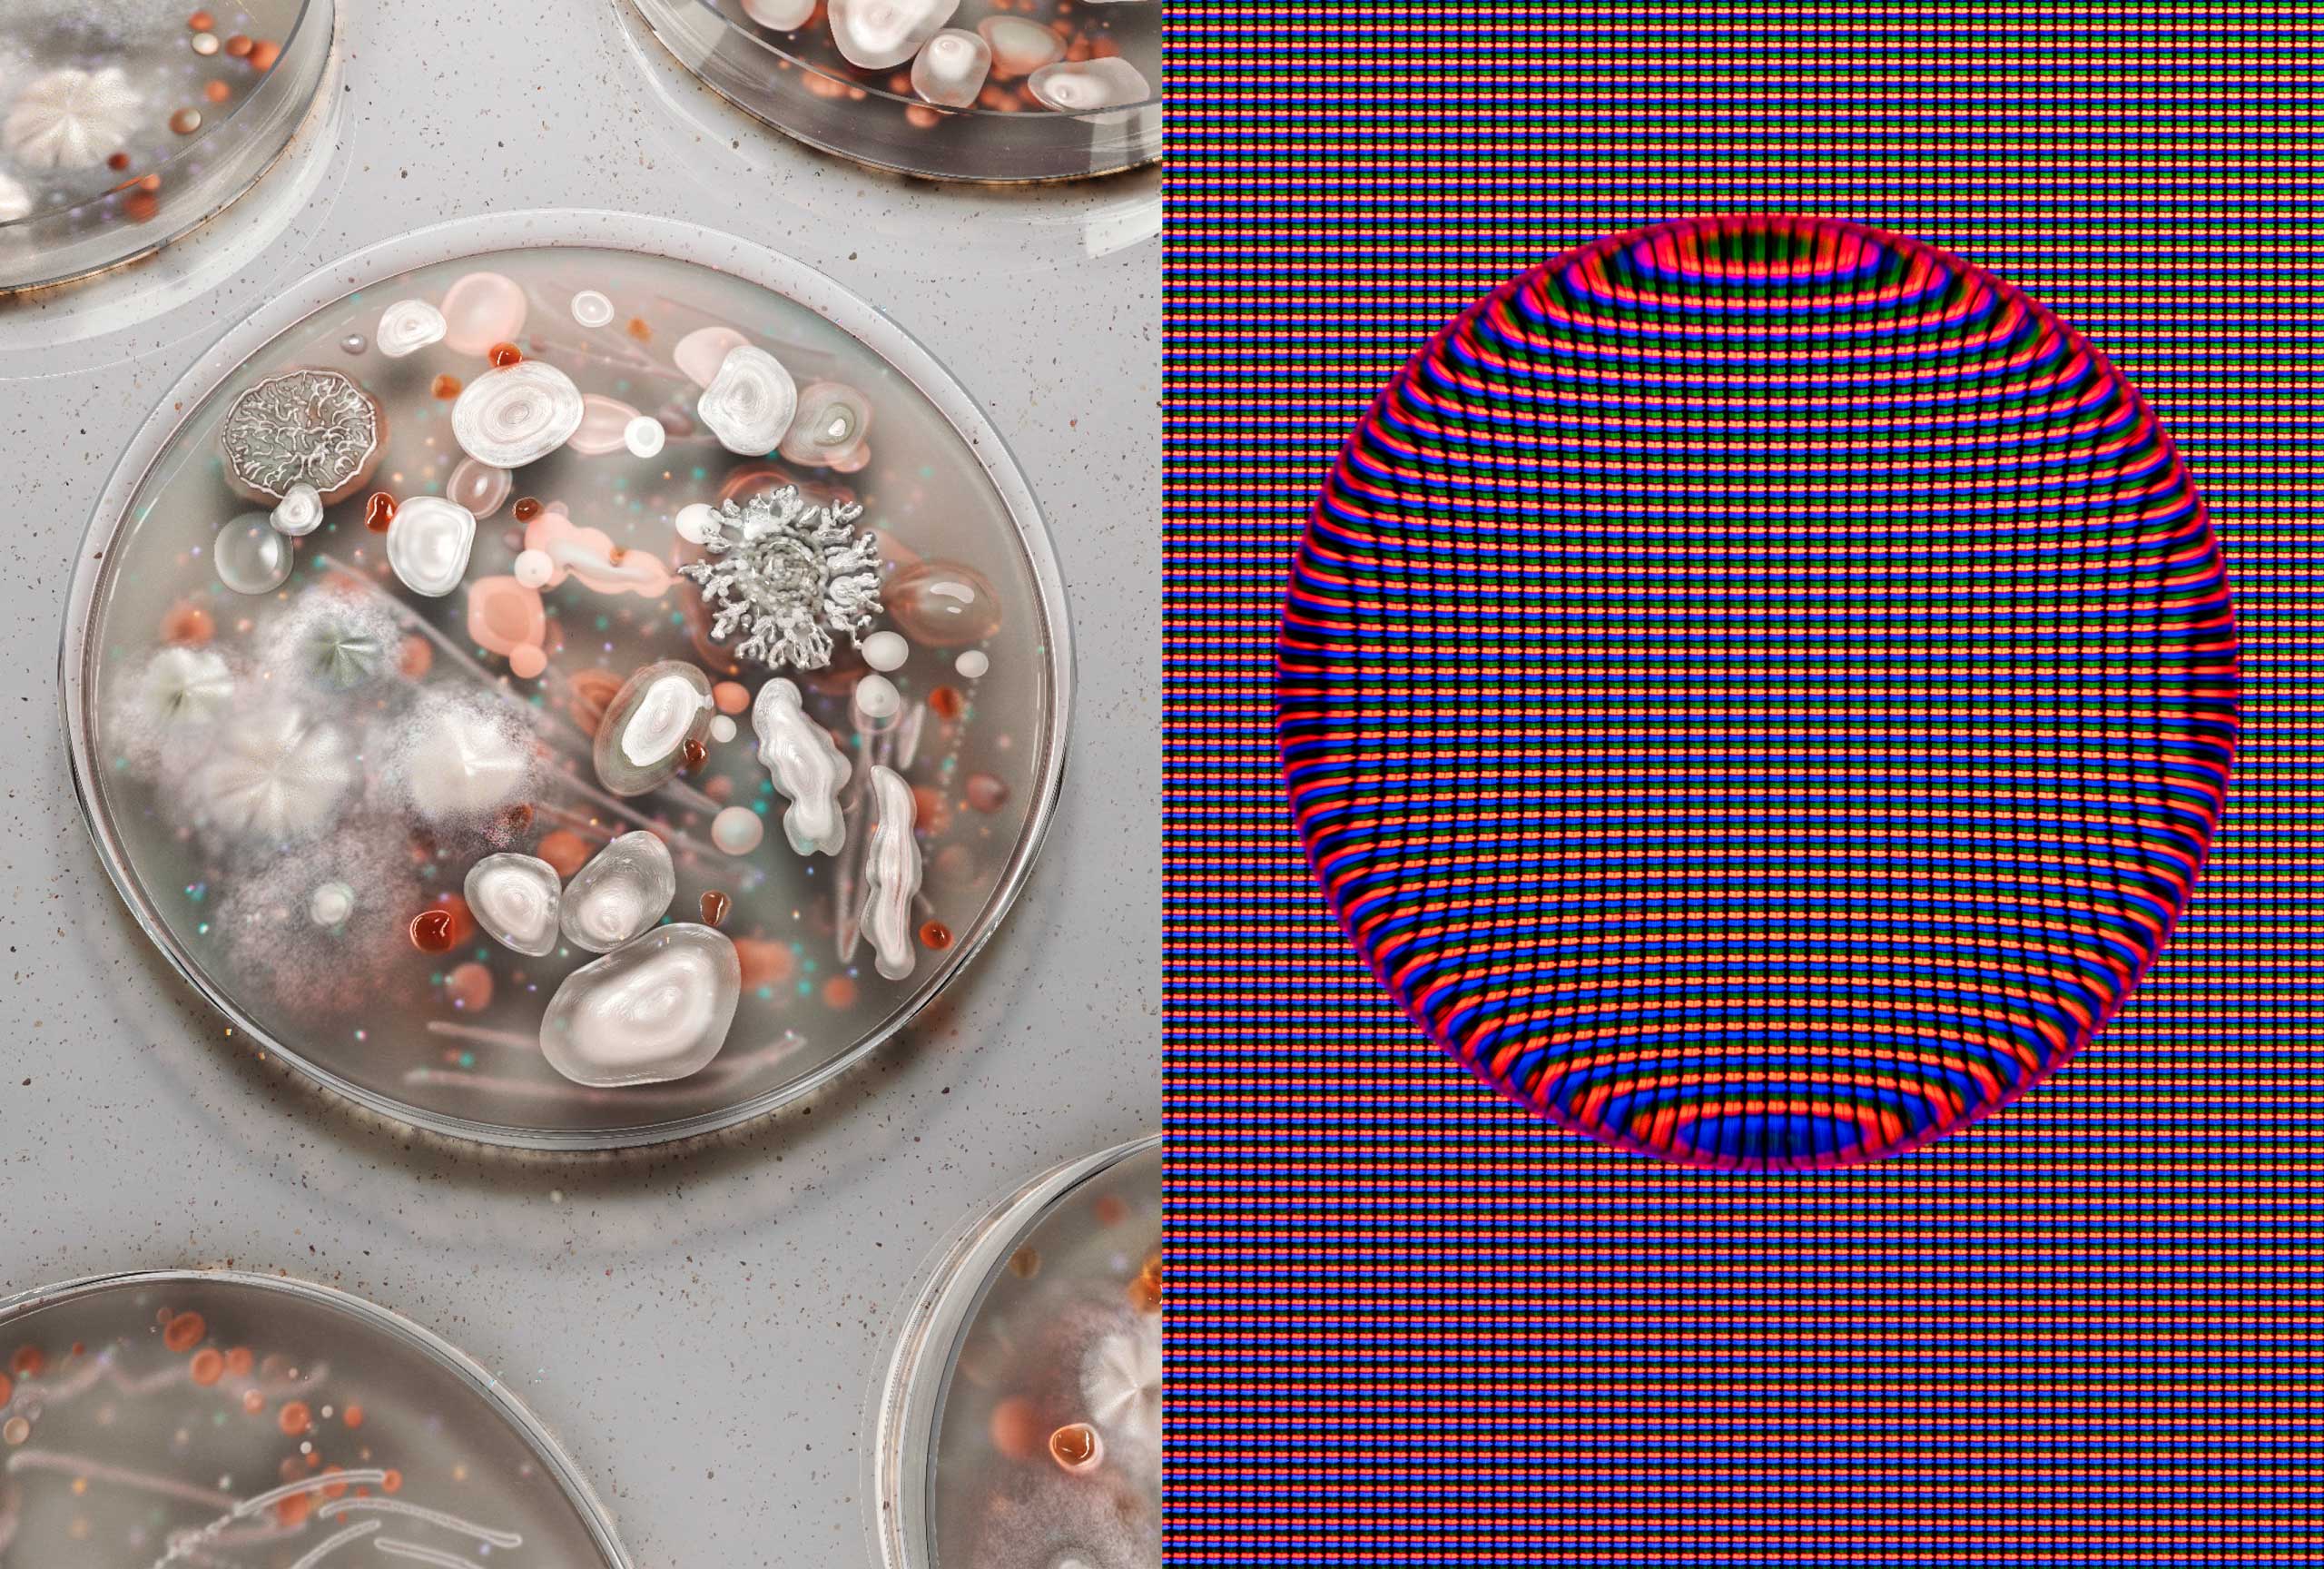
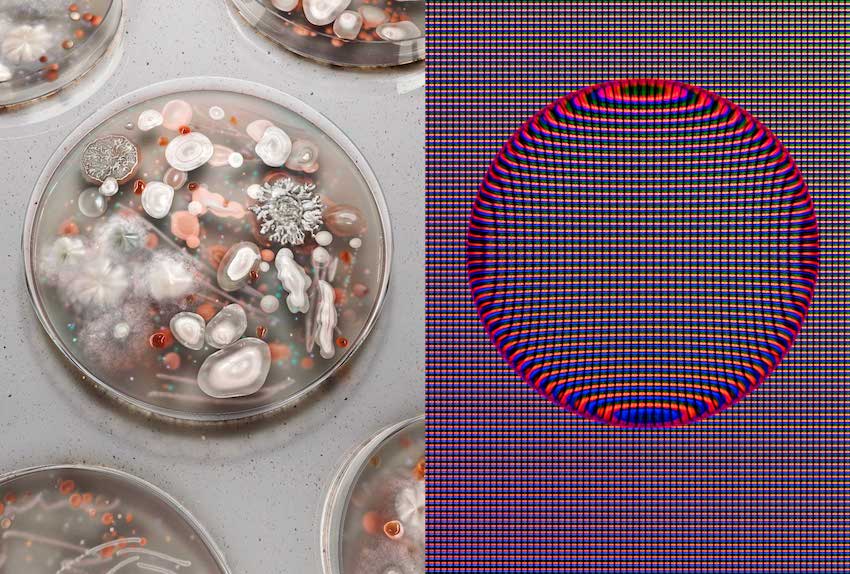

We are very pleased to share the digital edition of our Monograph, which anyone from around the world can enjoy, share and keep.
Published in 2017, the 300 page monograph is a snapshot in time of one of the world’s leading brand agencies. It is a reflection of the studio, our work, process and the insights behind it. Most of our work exists in motion, as digital experiences and on screens, so this book was a wonderful opportunity to curate and craft a beautiful object that embodies what we do.
We hope you enjoy reading as much as we enjoyed making it.
Explore Book